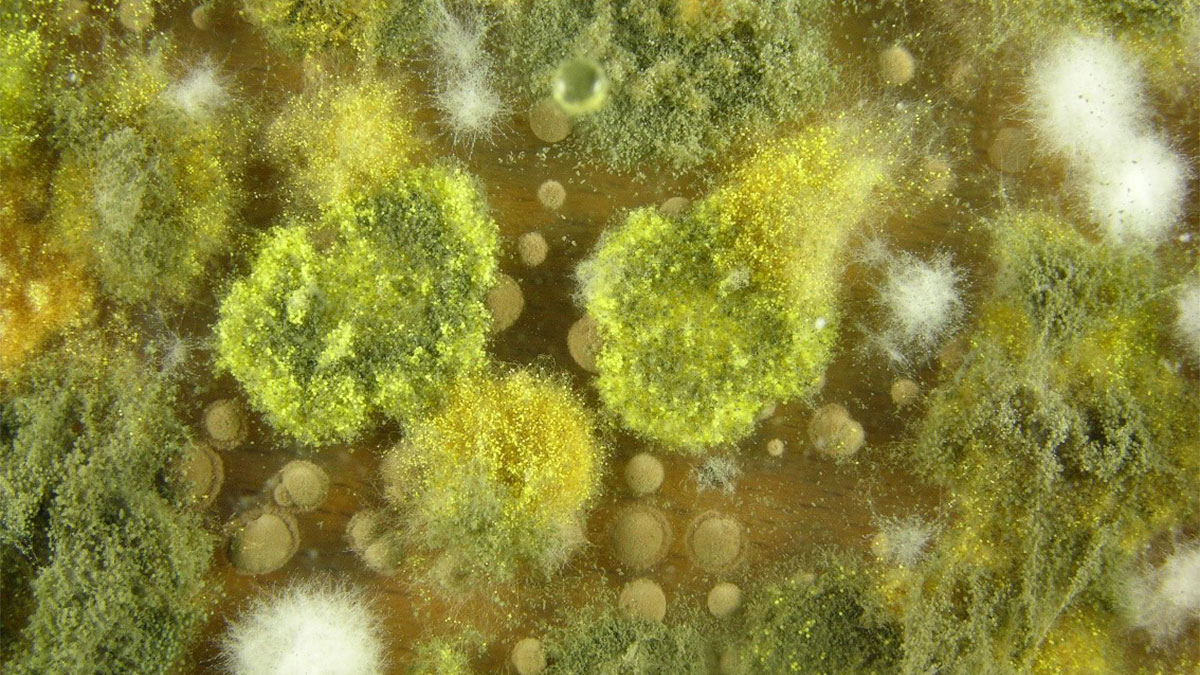

تاثیر کپک بر یبوست؛ بررسی علمی یک ارتباط ناشناخته
کپکها بخش طبیعی محیط زیست هستند و میتوانند روی مواد غذایی و در فضاهای مرطوب رشد کنند. برخی از این کپکها مایکوتوکسینهایی[1] تولید میکنند که مصرف آنها میتواند روی سلامت انسان اثر بگذارد. تهوع و استفراغ از مشکلات گوارشی شناختهشده هستند و مکانیسم بروز آنها به خوبی درک شده است. اما تأثیر مواجهه با کپک بر یبوست هنوز بهطور محدود بررسی شده است. در این مقاله قصد داریم شواهد موجود درباره تاثیر کپک بر یبوست و سایر مشکلات گوارشی را بررسی کنیم و راهکارهایی برای کاهش مواجهه با کپک و مایتوتوکسینها ارائه دهیم. با ما همراه باشید تا بیشتر با این موضوع آشنا شوید.
مایکوتوکسینها عامل تاثیر کپک بر یبوست

همانطور که در بخش مقدمه گفته شد، برخی کپکها موادی به نام مایکوتوکسین تولید میکنند که خوردن آنها ممکن است باعث مشکلات گوارشی و دیگر مشکلات سلامتی شود. بنابراین به طور نظری، تاثیر کپک بر یبوست امکانپذیر است. اما احتمال این اتفاق خیلی کم است.
کپکها اغلب روی مواد غذایی مختلف مانند آجیل، غلات، ادویهها، میوهها و قهوه رشد میکنند. برخی از این کپکها مواد سمی به نام مایکوتوکسین تولید میکنند که غذاها را آلوده میکند. یکی از راههای کاهش تأثیر کپک بر یبوست، خودداری از خوردن غذاهای کپکزده است. خوردن مواد غذایی آلوده به مایکوتوکسینها شاید همان لحظه مشکلات شدیدی ایجاد نکند. اما در دراز مدت میتواند باعث مشکلاتی برای سلامتی انسان شود. این مشکلات عبارتاند از:
- ضعیف شدن سیستم ایمنی
- افزایش خطر برخی سرطانها
- علائم گوارشی مانند حالت تهوع و استفراغ
در ادامه ارتباط بین قرارگیری در معرض کپک و بروز علائم گوارشی مانند یبوست را بررسی خواهیم کرد.
تأثیر کپک بر یبوست: احتمال یا واقعیت؟

برآورد میشود که حدود یکچهارم محصولات کشاورزی جهان، مانند آجیل و برنج، آلوده به کپک هستند. اما تنها برخی از این کپکها مایکوتوکسین تولید میکنندمصرف مداوم چنین غذاهایی میتواند سلامت بدن را تحت تأثیر قرار دهد.
تحقیقات نشان میدهند که بعضی مایکوتوکسینها میتوانند تعادل باکتریهای مفید روده (میکروبیوم روده) را بر هم بزنند. زمانی که این تعادل مختل شود، ممکن است یبوست عملکردی [2] ایجاد شود. یبوست عملکردی زمانی رخ میدهد که فرد حرکات رودهای نامنظم دارد بدون آنکه دلیل آن مشکل آناتومیکی مشخصی باشد.
ارتباط بین یبوست و مواجهه با مایکوتوکسینها عمدتا فرضی است و تقریباً هیچ تحقیقی وجود ندارد که این دو را به هم مرتبط کند .
برای کاهش نگرانی از بابت آلودگی مواد غذایی به مایکوتوکسینها، سازمان غذا و داروی آمریکا (FDA) برنامهای نظارتی تدوین کرده است که سلامت غذاهای خریداری شده و عاری بودن آنها از مایکوتوکسینها را تضمین میکند .برنامه نظارتی FDA عمدتاً بر انواع مایکوتوکسینهایی تمرکز دارد که برای انسان مضر شناخته شدهاند. در جدول زیر، فهرستی از مایکوتوکسینهای مضر برای سلامت انسان، اثرات احتمالی آنها و غذاهایی که معمولاً به این مواد آلوده میشوند، گردآوری شده است.
فهرست مایکوتوکسین های مضر برای انسان
| نام | تاثیر احتمالی | غذاهای در معرض خطر آلودگی |
| آفلاتوکسینها ( aflatoxins) | افزایش خطر سرطان کبد نقصهای هنگام تولد مشکلات کلیه و سیستم ایمنی نارسایی کبد یا مرگ در صورت مصرف مقادیر زیاد | بادامزمینی ذرت آجیلهای درختی مانند بادام برزیلی و پسته غلات ریز مانند برنج شیر گاوهایی که از محصولات آلوده مصرف کردهاند. |
| دئوکسی نیوالنول (deoxynivalenol) | استفراغ حالت تهوع | نان رشتهفرنگی آبجو پاپکورن |
| فومونیزینها ( fumonisins) | بیماری مغز، قلب، کبد و کلیه در حیوانات | گندم و ذرت |
| پاتولین ( patulin) | آسیب کلیه در حیوانات | میوه غلات پنیر |
| اوکراتوکسین A (ochratoxin A) | آسیب کلیه در حیوانات | غلاتی مانند گندم، چاودار، جو و جو دوسر قهوه انگور و شراب |
| توکسینهای HT2-T2 (T-2 and HT-2 toxins) | اختلال در تخمکگذاری و تولید اسپرم در حیوانات | غلاتی مانند گندم، چاودار، جو و جو دوسر |
| زئارالنون ( zearalenone) | مشکلات تولیدمثلی | ذرت ، جو ، گندم، سورگوم و برنج |
تاثیر کپک بر یبوست به واسطه استنشاق آن
کپکها ذرات ریزی به نام هاگ آزاد میکنند که میتواند ریه افراد حساس را تحریک کرده و علائم تنفسی ایجاد کند. این هاگها و دیگر مواد تحریککننده میتوانند سلولهای ایمنی به نام ماست سلها (mast cells) را فعال کنند و باعث ایجاد حالتی به نام سندرم فعالسازی ماست سلها [3] شوند.
تحقیقات نشان دادهاند که اختلال عملکرد ماست سلها میتواند خطر ابتلا به سندرم روده تحریکپذیر[4] افزایش دهد. افراد مبتلا به این سندرم ممکن است دچار یبوست و مشکلات گوارشی شوند.
سایر تأثیرات کپک بر دستگاه گوارش

مصرف محصولاتی که حاوی مایکوتوکسین هستند، ممکن است علاوه بر یبوست منجر به سایر علائم گوارشی نیز شود. در ادامه به برخی از این علائم اشاره شده است:
- نفخ
- ورم معده
- بوی بد دهان
- عدم تحمل بعضی غذاها
- حساسیت به برخی غذاها
- درد و گرفتگی شکم
- اسهال
- وجود مخاط در مدفوع
در موارد جدیتر، مصرف مقدار زیاد برخی مایکوتوکسینها میتواند خطرناک و حتی تهدیدکننده زندگی باشد. برای مثال، خوردن غذایی که حاوی مقادیر بالای آفلاتوکسین (Aflatoxin) است، میتواند باعث نارسایی کبد یا حتی مرگ شود.
عوارض جانبی قرار گرفتن طولانیمدت در معرض کپک
قرار گرفتن طولانیمدت در معرض برخی مایکوتوکسینها میتواند سلامت بدن را تهدید کند و خطر بروز مشکلاتی مانند ضعف سیستم ایمنی و سرطان را افزایش دهد. همچنین ممکن است مشکلات دیگری مانند آسیب به کلیهها وکبد و مشکلات هورمونی را در پی داشته باشد.
اکثر افراد روزانه در معرض مقادیر کمی از مایکوتوکسینها قرار میگیرند، زیرا این مواجهه تقریباً اجتنابناپذیر است. میزان اندک مایکوتوکسینها در برخی محصولات غذایی، تحت نظارت سازمان غذا و داروی آمریکا (FDA) ، مجاز است؛ مشروط بر اینکه این مقدار خطری برای سلامت انسان ایجاد نکند.
راهکارهای کاهش مواجهه با مایکوتوکسینها

اگر چه قرارگیری در معرض مایکوتوکسینها میتواند مشکلات گوارشی ایجاد کند، اما با چند راهکار ساده میتوان این احتمال را کاهش داد. در ادامه به این راهکارها پرداخته ایم:
- خرید غذای تازه و مصرف سریع آن پس از خرید
- نگهداری غذا در مکانهای تمیز و خشک
- تمیز کردن جعبه نان هفتهای یکبار با سرکه و آب و برداشتن خرده نانها
- دور ریختن غذاها و مایعات کپکزده
- خودداری از مصرف لبنیات کپکزده
- نگهداری غلات و آرد در جای خنک و خشک و تکان دادن آنها به طور منظم
- خرید میوه و سبزی سالم و بدون آسیب
- نگهداری مرباهای رژیمی در یخچال و دور ریختن مرباهای کپکزده
- دور ریختن نان حاوی کپک حتی در حد یک نقطه کوچک
- دور ریختن گوشت یا سوسیس کپکزده (در بعضی سوسیسهای خشکشده، قسمت سالم پس از بریدن کپک قابل مصرف است)
- مصرف سریع ادویهها
- پرهیز از دادن محصولات کپکزده به حیوانات خانگی، زیرا میتواند باعث بروز بیماری شود.
زمان مناسب مراجعه به پزشک

در صورت بروز یبوست مداوم یا مصرف داروهایی مانند اوپیوییدها (opioids) که میتوانند یبوست ایجاد کنند، مراجعه به پزشک توصیه میشود. همچنین مشاهده خون در مدفوع نیازمند بررسی فوری پزشکی است.
سخن پایانی
در مجموع، شواهد فعلی تاثیر کپک بر یبوست را به طور قطع تایید نمیکند اما تحقیقات نشان میدهند قرار گرفتن در معرض کپک ممکن است در برخی موارد با مشکلات گوارشی، از جمله یبوست، مرتبط باشد. این ارتباط هنوز به طور کامل تأیید نشده است و نیاز به مطالعات بیشتری دارد. یبوست معمولاً دلایل متعددی دارد و عوامل دیگری مانند رژیم غذایی، کمآبی بدن و سبک زندگی نیز نقش مهمی ایفا میکنند. رعایت بهداشت محیط، اجتناب از مصرف غذاهای کپکزده و مراقبت از سلامت گوارش میتواند به کاهش ریسک و بهبود وضعیت کمک کند. در صورتی که یبوست ادامه پیدا کند، مراجعه به پزشک توصیه میشود.
| mast cell activation syndrome | [3] | functional constipation | [2] | mycotoxins | [1] |
| irritable bowel syndrome | [4] |



